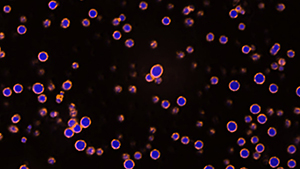

| Having trouble viewing this email? View as Webpage |

|
|
|
|
In a pair of studies, investigators from the lab of Huiping Liu, MD, PhD, have uncovered how specific cellular interactions in the bloodstream may be fueling the spread of breast cancer.
Read more
|

|
|
|
A new study led by the Naghavi Lab has uncovered a surprising molecular link between HIV-1 and a protein fragment associated with Alzheimer’s disease, according to findings published in the Proceedings of the National Academy of Sciences.
Read more
|

|
|
|
A team co-led by Wilton Snead, PhD, assistant professor of Cell and Developmental Biology, has found that paraspeckles, structures located in the nucleus of many cells, form differently than previously thought, which may aid in the design of future cancer drugs, per findings published in Proceedings of the National Academy of Sciences.
Read more
|
|
|
|
The Center for Advanced Microscopy (CAM) is now home to the first MIRAVA Polyscope in the nation — a super-resolution instrument by Abberior capable of 3D STED and 2D MINFLUX imaging. This cutting-edge technology achieves single-nanometer resolution, reaching as fine as three nanometers in biological samples.
Read more
|

|
|
|
|
|
|
|
Fumiaki Ito, PhD, joined Feinberg in September 2025 as an assistant professor of Microbiology-Immunology. His research focuses on the molecular basis of virus-host interactions, with a particular interest in viral replication, antiviral immunity and how viruses manipulate host cells. Using cryo-electron microscopy and biochemical approaches, the Ito Lab aims to uncover atomic-level insights into infection and immune defense that could inform future therapeutics for infectious diseases. Ito earned his PhD at the University of Southern California and completed a joint postdoctoral fellowship at USC and UCLA, where he received a prestigious NIH K22 Career Transition Award to support his research.
|

|
|
|
|
|
|
Congratulations to our faculty who were promoted in Fiscal Year 2026!
We’re proud to celebrate their achievements in advancing science, education and discovery at Feinberg and beyond.
Biochemistry and Molecular Genetics
Pharmacology
|
|
Leadership Update
Marc Mendillo, PhD, associate professor of Biochemistry and Molecular Genetics, has been named interim associate director for Education and Training at the Robert H. Lurie Comprehensive Cancer Center. In this role, he oversees education and training programs supporting scientists at all career stages, directs philanthropic resources for graduate training and helps guide the center’s strategic priorities. His research focuses on how cellular stress response systems drive malignant growth and resistance to therapies.
|

|
|
|
|
|
Congratulations to Wen Lu, PhD, research assistant professor of Cell and Developmental Biology in the Gelfand Lab, whose image was recently featured on the cover of the journal Development. The image shows a wild-type Drosophila (fruit fly) larval brain and a mutant brain lacking the mitotic motor kinesin-5 in neurons.
Lu was also recently selected as this year's commissioned artist for the Genesee Drosophila Art Contest. Combining her scientific expertise with her artistic passion, she integrates science and art to enhance scientific communication. Her winning artwork, "An Odyssey of Wonder," was inspired by her daily scooter rides through downtown Chicago along Lake Michigan.
|
|
|
|
Recognizing Faculty Excellence at 2025 Driskill Day
At the 2025 Driskill Day celebration, Megan Roy-Puckelwartz, PhD, assistant professor of Pharmacology, was recognized with the Dean's Teaching Award, and Hank Seifert, PhD, the John Edward Porter Professor of Biomedical Research and professor of Microbiology-Immunology, received the Faculty Service Award. Congratulations to both faculty members on these well-deserved honors.
|

|
|
Mario Garcia Named 2025-26 Julius B. Kahn, Jr. Fellow
Mario Garcia has been named the 2025-26 Julius B. Kahn, Jr. Fellow by the Department of Pharmacology. Garcia is a PhD candidate in the Driskill Graduate Program working in the Rocklin Lab, where he investigates the protein energy landscapes of nanobodies and seeks to identify design principles that govern their stability and conformational fluctuations.
As part of the fellowship, Garcia will receive a stipend, travel/research support and host a visiting professor for the annual Julius B. Kahn, Jr. Lectureship, which honors the late Dr. Julius B. Kahn, Jr., chair of the department from 1966 to 1968. The lecture will take place in spring 2026.
|

|
|
Research Day Poster Competition Winners
At Feinberg’s 19th annual Lewis Landsberg Research Day on September 11, the following trainees were recognized for their outstanding poster presentations:
- Jessica Christiansen, research technologist in the Penzes Lab, won second place in Basic Science Research for her poster, "Mutations in KALRN are Linked to Neurodevelopmental Disorders."
- Josiah Wong, DGP student in the Yue Lab, received third place in Basic Science Research for his poster titled, "Targeting SUV39H1/2-Mediated H3K9ME3 Induces Transposon Element Reactivation in Acute Myeloid Leukemia."
- Fangjia Tong, PhD, postdoctoral fellow in the Liu Lab received the Award for Excellence in Women’s Health Research in Basic Science for her poster, "Computational Ranking Identifies Plexin-B2 in Circulating Tumor Cell Clustering with Monocytes in Breast Cancer Metastasis."
|
|
|
|
|
Eric Villamiel is the senior financial administrator for the Basic Science Administration (BSA) Finance team. In his role, he leads a team of five dedicated to ensuring basic science departments and centers at Feinberg receive the financial services and procurement support they need.
Read a Q&A
|

|
|
|
|
Research Security Training – Required by Oct. 1, 2025
As previously communicated, the federal government is moving toward requiring Research Security training for researchers applying for or receiving federal funding. To ensure compliance among all federal agencies, Northwestern will require all principal investigators and senior/key personnel working on a federal award or submitting a proposal to a federal agency, to complete this training by October 1, 2025.
Researchers should complete the 1-hour Northwestern-developed training available through myHR Learn.
When Does Research Security Training Verification Occur?
Completion of training will be verified by both the research administrator (RA) and Sponsored Research (SR) prior to:
- Proposal submission
- JIT
- Award execution
- Personnel change requests
- Addition of new subawards
- RPPR submissions
Faculty with Dual Appointments
Faculty with dual appointments (e.g., Lurie Children’s, Shirley Ryan AbilityLab and Northwestern Medicine) should use their Northwestern University login credentials (NetID and NU email) to take the Northwestern training via myHR. If you have technical difficulties, contact NUIT for assistance. If you are unable to resolve the issue, please contact Export Controls and International Compliance.
|
|
New Domestic and International Shipping Service
Northwestern University has launched a new program, eShipGlobal, to streamline all outbound domestic and international shipments.
📦 eShipGlobal Training
Date: Wednesday, October 1, 2025
Time: 2:00 p.m. – 3:00 p.m.
Location: Via Zoom
Zoom Link: Join Meeting
This training session will cover the use of eShipGlobal for generating shipping labels and managing lab shipments. Attendance is encouraged for all designated lab members.
To support lab operations, all shipping label requests should be submitted through the PO Tool (log in using the VPN). Until designated lab personnel have completed the training (listed above), BSA Procurement will generate and send the appropriate shipping label to the lab.
When submitting a PO Tool request, please include the following details in the Notes/Comments section:
- Item/Product details
- Shipping address
- Package weight
- Any other relevant information (e.g., contents, urgency, special handling instructions)
Please also confirm that the sender completed the Safe Shipping Certification in Lumen titled, "Safe Shipping of Biological Materials or Dry Ice." This certification is required before packages containing biological materials or dry ice can be shipped.
|
|
|
|
|
|
|
|

